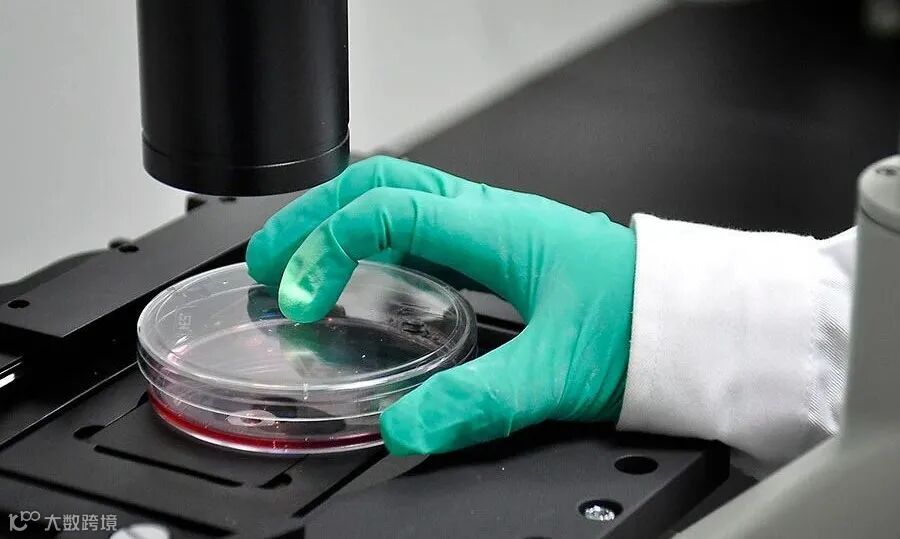

近日,2021年度新型研发机构认定结果发布,此次我市新增新型研发机构32家,其中新型高端研发机构9家、初创型23家。截至目前,我市共引进和培育新型研发机构179家,其中新型高端研发机构77家,新型研发机构数量居西部第一。
小新了解到,此次新认定的32家新型研发机构中,重庆国际免疫研究院、重庆邮电大学工业互联网研究院、重庆市綦齿齿轮研究院有限公司等9家单位为新型高端研发机构,重庆连芯光电技术研究院有限公司、重庆真测科技股份有限公司等23家单位为初创型新型研发机构。
从认定条件来看,要成为新型研发机构,必须迈过在职研发人员比例不低于机构总人数的50%、科研活动收入比重不低于经营收入的50%等“门槛”,以制造、生产、销售为主的法人主体,以及单纯提供技术服务而研发比重不足的企业,均不会被认定。
据悉,此次新认定的32家新型研发机构中,由重庆邮电大学和重庆仙桃数据谷投资管理有限公司共建的重庆邮电大学工业互联网研究院,科研人员占比达94.20%,上一年度R&D占比高达88.44%。
此外,认定要求机构必须为在渝注册独立法人,并鼓励龙头企业、高校、科研院所联合共建资源共享、机制灵活、运行高效的新机构。此次新认定的32家机构,从机构性质来看,企业类24家、事业单位类5家、民办非企业类3家;从机构发起主体来看,高校发起9家、科研院所发起3家、企业发起20家,真正体现出有别于传统科研机构的“新”。
市科技局有关负责人表示,近年来,重庆坚持高质量培育和引导新型研发机构,推动新型研发机构形成了突出研发职能定位、聚焦重庆产业需求、形成区域带动示范等特点。

科研人员们进行纤维材料的相关试验
图 | 重庆日报 万难 摄 /视觉重庆
据介绍,在此次新认定的新型研发机构中,聚焦战略新兴产业的有27家,占比达84%,排名前三的分别是生物医药、智能机器人、智能制造。这些新型研发机构对重庆产业发展的带动作用正逐步显现。
比如,重庆国际免疫研究院致力于打造集理论和技术原创研究、创新技术应用研究和创新免疫生物制品研发的高水准研究平台,已启动部署原创基础研究15项,技术转化研究21项。重庆市綦齿齿轮研究院有限公司聚焦商用车智能化、电动化发展趋势,着重解决商用车齿轮传动关键核心技术,近两年来获批国家级项目1项、市级以上研发项目5项,获得国家科技奖1项。
值得一提的是,此次新认定的新型研发机构中,位于西部(重庆)科学城和两江新区的有16家,占比超过50%;位于各级高新区的有14家,占比44%。
截至目前,我市新型研发机构拥有研发人员6047人,占全市科研院所科研人员总数的45.75%。其中博士及以上学历人员1231人,引进高层次人才667人,柔性引进院士团队14个,新型研发机构引育初见成效。
数据显示,2021年,重庆市新型研发机构年度科研活动总收入预计将超过40亿元,年度研发投入预计将达到21亿元,增长20%以上。
来源:重庆日报
记者:张亦筑

│大家都爱读│




